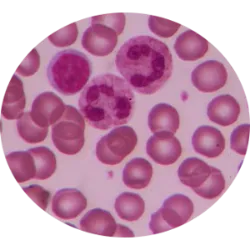

Informar y combatir la enfermedad: cuándo es y por qué el 25 de octubre
El 25 de octubre es el día del síndrome mielodisplásico (MDS) , un trastorno de la médula ósea que impide la producción de células sanguíneas maduras y funcionales
La médula ósea se encarga de generar tres tipos de células sanguíneas: glóbulos rojos (transportan oxígeno), glóbulos blancos (defienden el organismo) y plaquetas (importantes para la coagulación). La jornada tiene como objetivo crear conciencia sobre los SMD y promover la investigación y el tratamiento, ya que estas afecciones pueden provocar complicaciones graves como la leucemia. La fecha resalta la importancia de reconocer los síntomas y realizar exámenes periódicos para facilitar el diagnóstico precoz.










